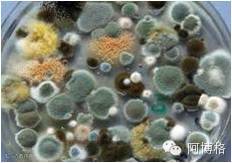

12月1日的深圳和12月3日的上海,ARBURG(阿博格)诚邀来自瑞士HB-Therm公司的模具温度控制专家Kurt Klopfenstein先生向中国客户介绍了关于模具温度控制方面的课题。
主要涉及:
温度控制技术
温度控制的优化
动态模温注塑工艺
那么,为了弥补没有参与讲座的网友的遗憾。我们也将通过ARBURG(阿博格)官方微信分期详细介绍。
过去两周,我们介绍了HB-Therm公司以,温度控制技术以及温度控制的优化的部分内容,本周我们将继续介绍有关温度控制优化的内容。
水处理在温度控制的优化利用中也非常重要,如果对水质不加以管控,将会有非常严重的后果。
温度控制回路中的污垢:
石灰垢沉积

微生物沉积(淤泥)

热传递的损失取决于石灰垢

水的主要性能

对水质不加以管控的后果:
鳞屑/污垢


腐蚀


生物沉积

温度控制回路中的水质标准值

冷却水和系统水分离的原理

规划水处理系统的程序
评估(什么级别的水提供给哪种电器)
为现有设备选择合适的概念
确认温度控制单元是否符合水处理建议措施
水处理设备的尺寸测量
温度控制单元的措施:
冷却水和系统水分离
出口温度低,冷却水不蒸发
密封电路(不接触空气)
净化
温度控制电路无蒸发
耐腐蚀性
加热元件不直接与传热介质接触
循环系统水交换
避免见光
防止水质不良的结果:
减少故障,磨损和维护至最低
模具寿命更长
水处理不仅对温度控制重要,对整个注塑系统都有非常大的影响。更多关于水处理,请点击“阅读原文”,参与我们的活动获取更多资讯哦!



